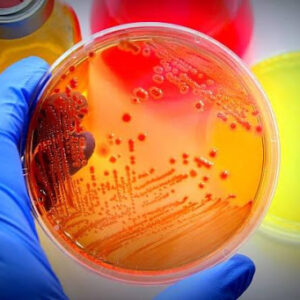

FORNECEDOR DE MATERIAIS DE LABORATÓRIO
Trabalhamos há mais de 25 anos como fornecedor de ponta para toda a linha Vacuette e variedade completa de materiais para laboratórios, incluindo aparelhos de processamento para exames humanos e veterinários.
+ de 25 anos no mercado
Compra garantida
Cotação facilitada
Chame no WhatsApp
Equipe especializada
Te Ajudamos na Compra
frete rápido
Faça sua Simulação
CATEGORIAS DE PRODUTOS
SOBRE A LABTECH
NOSSA HISTÓRIA
Nossa empresa, fundada em 1997, tem um forte compromisso com a inovação e o sucesso no mercado. Entendemos que um cenário empresarial em constante evolução requer uma equipe de liderança moderna e experiente, por isso temos muito orgulho de contar com ambas. Nossa equipe administrativa está constantemente trabalhando para se manter na vanguarda das tendências do setor e para investir nos recursos necessários para manter nossa vantagem competitiva. Acreditamos que investir em nossas pessoas, processos e tecnologia se traduz diretamente em valor para nossos clientes. Com foco em inovação, uma equipe dedicada e um compromisso com a melhoria contínua.


















Endereço
R. Potiguares, 88 - Tatuapé
São Paulo - SP, 03065-010
Telefone
(11) 2941-5400
Segunda a Sexta-feira: 08h às 17h
11 94739-9188
Segunda a Sexta-feira: 08h às 17h
site@labtech.com.br
Envie-nos um e-mail a qualquer momento!